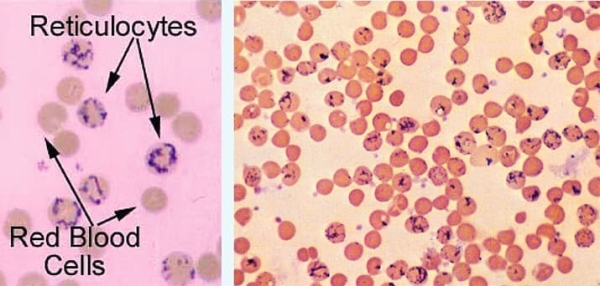
Гемолитические анемии у детей: клиника и алгоритм диагностики			     
        Гемолитические анемии у детей: клиника и алгоритм диагностики

Гемолитические анемии у детей: клиника и алгоритм диагностики

Фото носит иллюстративный характер. Из открытых источников.
В РНПЦ РМиЭЧ проанализировали заболеваемость гемолитическими анемиями в Беларуси за 2005–2020 годы. Также специалисты центра изучили протоколы обследования и лечения детей с диагнозами D55–D59 по МКБ-10, данные литературы и на их основе разработали собственный алгоритм диагностики, который может использоваться на всех уровнях оказания медицинской помощи и позволяет с минимальными затратами определять основные виды гемолитических анемий у детей. Подробнее рассказала врач —детский онколог-гематолог онкологического гематологического отделения для детей РНПЦ РМиЭЧ Екатерина Мицура.
Важность вопроса

Екатерина МицураГемолитические анемии — это группа заболеваний, для которых характерно повышенное разрушение эритроцитов, обусловленное сокращением продолжительности их жизни. При необходимости нормальный костный мозг гиперплазируется и может увеличить в 6–8 раз продукцию клеток любой линии гемопоэза, в т. ч. эритроцитов. Поэтому продолжительность жизни эритроцитов может уменьшаться с 120 до 15–20 дней без развития анемии.
Равномерное увеличение деструкции и продукции эритроцитов приводит к компенсированному гемолизу и не сопровождается анемией. Гемолитическая анемия развивается в случаях, когда длительность жизни эритроцитов настолько мала (менее 15 суток), что гиперплазированный костный мозг не может обеспечить адекватную продукцию клеток эритроидного ряда.
Внутриорганный (внутриклеточный) гемолиз сопровождается спленомегалией, гепатомегалией и гипербилирубинемией; внутрисосудистый — гемоглобинемией, гемоглобинурией, гемосидеринурией, метгемоглобинемией, ДВС-синдромом; смешанный — сочетанием признаков внутриорганного и внутрисосудистого гемолиза.
Гемолитические анемии бывают наследственными (гемолиз вызван внутренними аномалиями эритроцитов — мембранопатиями, ферментопатиями, гемоглобинопатиями) и приобретенными (гемолиз вызван внешними (экстрацеллюлярными) воздействиями — иммунными или неиммунными). К мембранопатиям (нарушениям структуры мембраны эритроцитов) относятся микросфероцитоз, эллиптоцитоз, стоматоцитоз и др.
Ферментопатии (нарушение активности ферментов пентозофосфатного цикла, гликолиза и др.) — дефицит глюкозо-6-фосфатдегидрогеназы, пируваткиназы и др. Гемоглобинопатии (нарушение структуры или синтеза гемоглобина) — талассемии, серповидноклеточная анемия.
Приобретенные гемолитические анемии могут быть связаны с иммунными (изоиммунными, аутоиммунными) воздействиями, механическим повреждением эритроцитов (клапанное поражение, гемодиализ, маршевая гемоглобинурия), воздействием физических факторов (термических), химических агентов, медикаментов, ядов, обусловлены инфекцией (малярия, токсоплазмоз, цитомегаловирус, сифилис).
Екатерина Мицура:
Мы проанализировали заболеваемость гемолитическими анемиями за 2005–2020 годы в Республике Беларусь. По нашим данным, средняя заболеваемость гемолитическими анемиями составила 1,79 на 100 тысяч детского населения, а годовая динамика характеризовалась отсутствием значимого роста.
По словам специалиста, с возрастом заболеваемость убывает. Так, в структуре 69,6 % приходится на детей первого года жизни (заболеваемость 11 на 100 тысяч населения в данной возрастной группе), 15,9 % — на возрастную группу 1–4 лет (заболеваемость 2,5 на 100 тысяч), 6 % — 5–9 лет, 4,7 % — 1–14 лет, 4 % — 15–17 лет.
Также специалисты изучили структуру гемолитических анемий у детей за 2017–2020 годы (n=134, что составляет 94 % от общереспубликанского уровня). Из всех случаев 79,9 % составили наследственные гемолитические анемии, 20,1 % — приобретенные. Среди наследственных форм чаще диагностировался наследственный сфероцитоз — 50,8 %, а также талассемия — 16,4 %, анемия вследствие ферментных нарушений — 3 %. Среди приобретенных 15,7 % составила аутоиммунная гемолитическая анемия.
Общее число состоящих на диспансерном учете по поводу гемолитических анемий в Беларуси на конец 2020 года — 16,1 на 100 тысяч детского населения. Распространенность наследственного сфероцитоза — 8,18 на 100 тысяч детского населения, или 1 случай на 12,2 тысячи детского населения.
Симптоматика различных видов
Екатерина Мицура:
Клиническое течение различных видов анемий характеризуется развитием синдромов анемии, гемолиза, перегрузки железом, гиперспленизма (талассемия), сидеропении, неэффективного эритропоэза.
Гемолиз клинически проявляется желтушным окрашиванием слизистых и склер, изменением цвета мочи (особенно при внутрисосудистом гемолизе), спленомегалией (наследственные гемолитические анемии: микросфероцитоз, талассемия). Может протекать перманентно или эпизодически (в виде кризов).
Развитие гемолитического криза характеризуется резким снижением уровня гемоглобина и эритроцитов с одновременным нарастанием ретикулоцитоза, повышением уровня свободного билирубина (особенно при внутриклеточном гемолизе), болями в животе, потемнением мочи (вплоть до черного цвета при внутрисосудистом гемолизе), увеличением температуры тела (до фебрильных чисел).
Признаки гемолиза по ОАК:
Ретикулоцитоз, отмечает эксперт, является характерным признаком гемолитических анемий, отражает регенераторную способность костного мозга (см. рис. 2).
Рисунок 1. Морфология эритроцитов.

Рисунок 2. Ретикулоцитоз.
В БАК при гемолизе наблюдаются:
Анализ мочи при гемолизе характеризуется повышением уробилина, появлением гемосидерина, свободного гемоглобина.
Для мембранопатий, прежде всего наследственного сфероцитоза, характерно снижение осмотической резистентности эритроцитов. Однако, по словам специалиста, классический тест требует больших временных и трудозатрат и обладает невысокой чувствительностью и специфичностью. Исследование после 24-часовой инкубации в термостате при 37 °С вызывает усиление гемолиза, повышая чувствительность теста. Для увеличения точности исследования предложены различные методики определения осмотической резистентности эритроцитов с помощью проточной цитометрии.
Для диагностики гемоглобинопатий проводится электрофорез гемоглобинов; ферментопатий — скрининг на дефицит ферментов — глюкозо-6-фосфатдегидрогеназы и других в зависимости от возможностей центра.
Иммунные гемолитические анемии выявляют при помощи пробы Кумбса. Прямой антиглобулиновый тест (прямая реакция Кумбса) используется для определения наличия на поверхности мембран эритроцитов эритроцит-связывающих антител (IgG) или компонентов системы комплемента (С3). Эритроциты больного инкубируют с антителами к человеческим иммуноглобулинам IgG и С3.
Если антитела класса IgG или С3 связываются с мембраной эритроцитов, происходит агглютинация эритроцитов — положительный результат, что свидетельствует о наличии аутоантител к эритроцитам. Может иметь место ложноположительный результат, который не всегда соответствует гемолизу. Таким образом, результаты неизменно должны коррелировать с клиническими проявлениями и симптомами.
Наследственный сфероцитоз
Екатерина Мицура:
Одной из наиболее частых наследственных гемолитических анемий в мире является наследственный сфероцитоз. К его типичным проявлениям относятся гемолитическая анемия, желтуха, ретикулоцитоз, образование камней в желчном пузыре, спленомегалия и наличие сфероцитов в мазке периферической крови, а также сниженная осмотическая стойкость эритроцитов. Кроме того, имеется положительный семейный анамнез.
При наследственном сфероцитозе отмечается классическая триада — анемия, спленомегалия (может достигать значительных размеров) и желтуха.
Признаки наследственного сфероцитоза по ОАК:
Морфология эритроцитов: более 10 % сфероцитов.
Показатели гемограммы у детей с наследственным сфероцитозом:
Екатерина Мицура:
Мы проанализировали протоколы обследования и лечения детей с гематологическими заболеваниями (D55–D59 по МКБ-10), данные литературы и на их основе разработали собственный алгоритм диагностики гемолитических анемий у детей (см. рис. 3). На первом этапе (амбулаторном, районный уровень) у пациента с признаками гемолитической анемии (анемия, повышение ретикулоцитов, общего и несвязанного билирубина, ЛДГ, снижение гаптоглобина) уточняется семейный анамнез (наследственный сфероцитоз у близких родственников).
В случае наличия наследственного сфероцитоза в семейном анамнезе учитываются значения гематологических показателей и индексов. У детей первого года жизни при значениях MCHC/Ht >1,06, Hb/MCHC ≤ 3,11, Hb/RDW ≤ 7,26, MCHC/MCV > 0,45, а у детей старше года при MCHC/MCV > 0,44, MCHC > 35,4 г/дл может быть установлен диагноз «наследственный сфероцитоз». При этом подходе не требуется направлять пациентов на следующие этапы оказания медпомощи и применять дорогостоящие методы лабораторной диагностики. При иных значениях MCHC/Ht, Hb/MCHC, Hb/RDW, MCHC/MCV, MCHC — переход на этапы 2 или 3.
Рисунок 3. Алгоритм диагностики гемолитических анемий у детей.

На втором этапе (стационарном, районный и областной уровень) у пациентов с отсутствием семейного анамнеза также проводится оценка значений гематологических показателей и индексов. У детей первого года жизни при значениях MCHC/Ht >1,06, Hb/MCHC ≤ 3,11, Hb/RDW ≤ 7,26, MCHC/MCV > 0,45, а у детей старше года при MCHC/MCV > 0,44, MCHC > 35,4 г/дл проводится тест осмотической резистентности эритроцитов методом проточной цитометрии (инструкция по применению № 054-0620 от 16.12.2020 «Метод определения осмотической резистентности эритроцитов с использованием проточной цитометрии») или классическим методом, при снижении осмотической резистентности также может быть выставлен диагноз «наследственный сфероцитоз». При иных значениях MCHC/Ht, Hb/MCHC, Hb/RDW, MCHC/MCV, MCHC следует исключить приобретенные гемолитические анемии, для этого применяется проба Кумбса.
Положительная проба Кумбса соответствует иммунным гемолитическим анемиям — изоиммунным, аутоиммунным, идиопатическим с тепловыми антителами, вторичным на фоне инфекционных заболеваний. При отрицательной пробе Кумбса гемолитическая анемия считается неиммунной, исключаются иные возможные причины гемолитической анемии: инфекции (вирусные, бактериальные, паразитарные); лекарственные средства и химические агенты; гематологические заболевания. При невозможности установить причину гемолитической анемии — переход к этапу 3.
На третьем этапе (стационарном, областной и республиканский уровень) уточняется диагноз других наследственных форм гемолитической анемии. Для этого выполняется электрофорез гемоглобина для подтверждения группы гемоглобинопатий (талассемии или серповидноклеточной анемии), поиск ферментопатий (определение активности глюкозо-6-фосфатдегидрогеназы и других в зависимости от возможностей центра), других мембранопатий. Для диагностики наследственного сфероцитоза на данном этапе может использоваться тест связывания с красителем эозин-5-малеимидом.
При отсутствии установленного диагноза после выполненных исследований проводятся исследование костного мозга, генетическое тестирование и другие тесты по показаниям.
Источник: medvestnik.by
